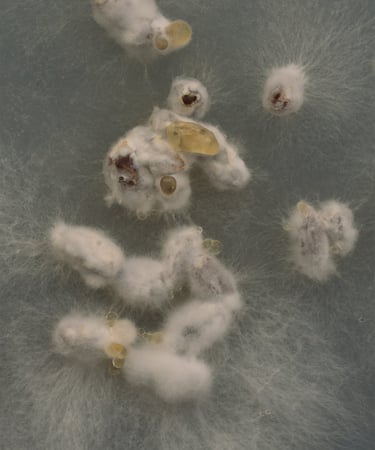
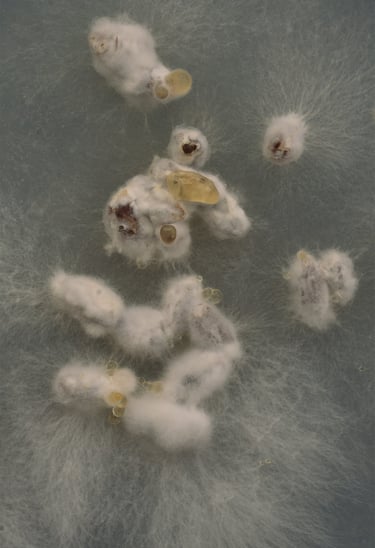

Kommende events i AVAL




Læse- og diskussionsgruppe om kunst og bæredygtighed
Dato: 06.11.25 kl. 17-19
Laboratorieworkshop i Bæredygtige Kunstmaterialer - Kombucha
Dato: 13.11. 25 - kl. 17:00 - 19:00

Masterclass; Rhizomatiske formationer: Introduktion til mycelium som materiale og kunstnerisk metode ved billedkunstner Pernille Emilia Kjær
Dato: 04.12. 25 - kl. 17:00 - 19:00